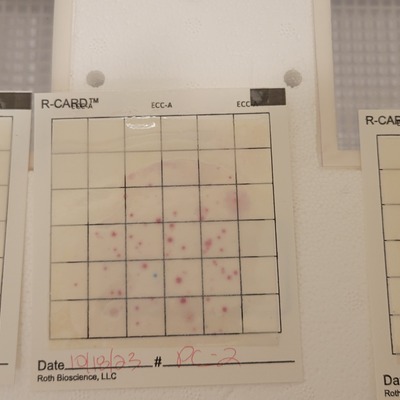

Location
Pelahatchie Creek
Pelahatchie Bay
Pelahatchie Bay in Mississippi
Dataset summary
Pelahatchie Creek has data for previous_weather_description, ph, oxygen, total_coliform, current_weather, incubation_temperature, incubation_time, water_depth, previous_weather, e_coli, alkalinity, turbidity, hardness, other_coliform, water_temperature, air_temperature, current_weather_description, secchi_depth, river_stage, taxa, civ, Ice on, and flow from 27 April 2018 to 28 February 2026.
- Water body type Lake
- Dataset Mississippi Water Stewards, Mississippi State University
- Data collector Abby Braman
- Location description
- Watercraft launch to the inlets of Pelahatchie Bay and Pelahatchie Creek. Calm water with wetlands. Baypoint Golf Course, fishing, bird watching, boating and other recreational activities. Test from the boat ramp at the Fishing Pier parking lot, not at the Pelahatchie Bay Trading Post.